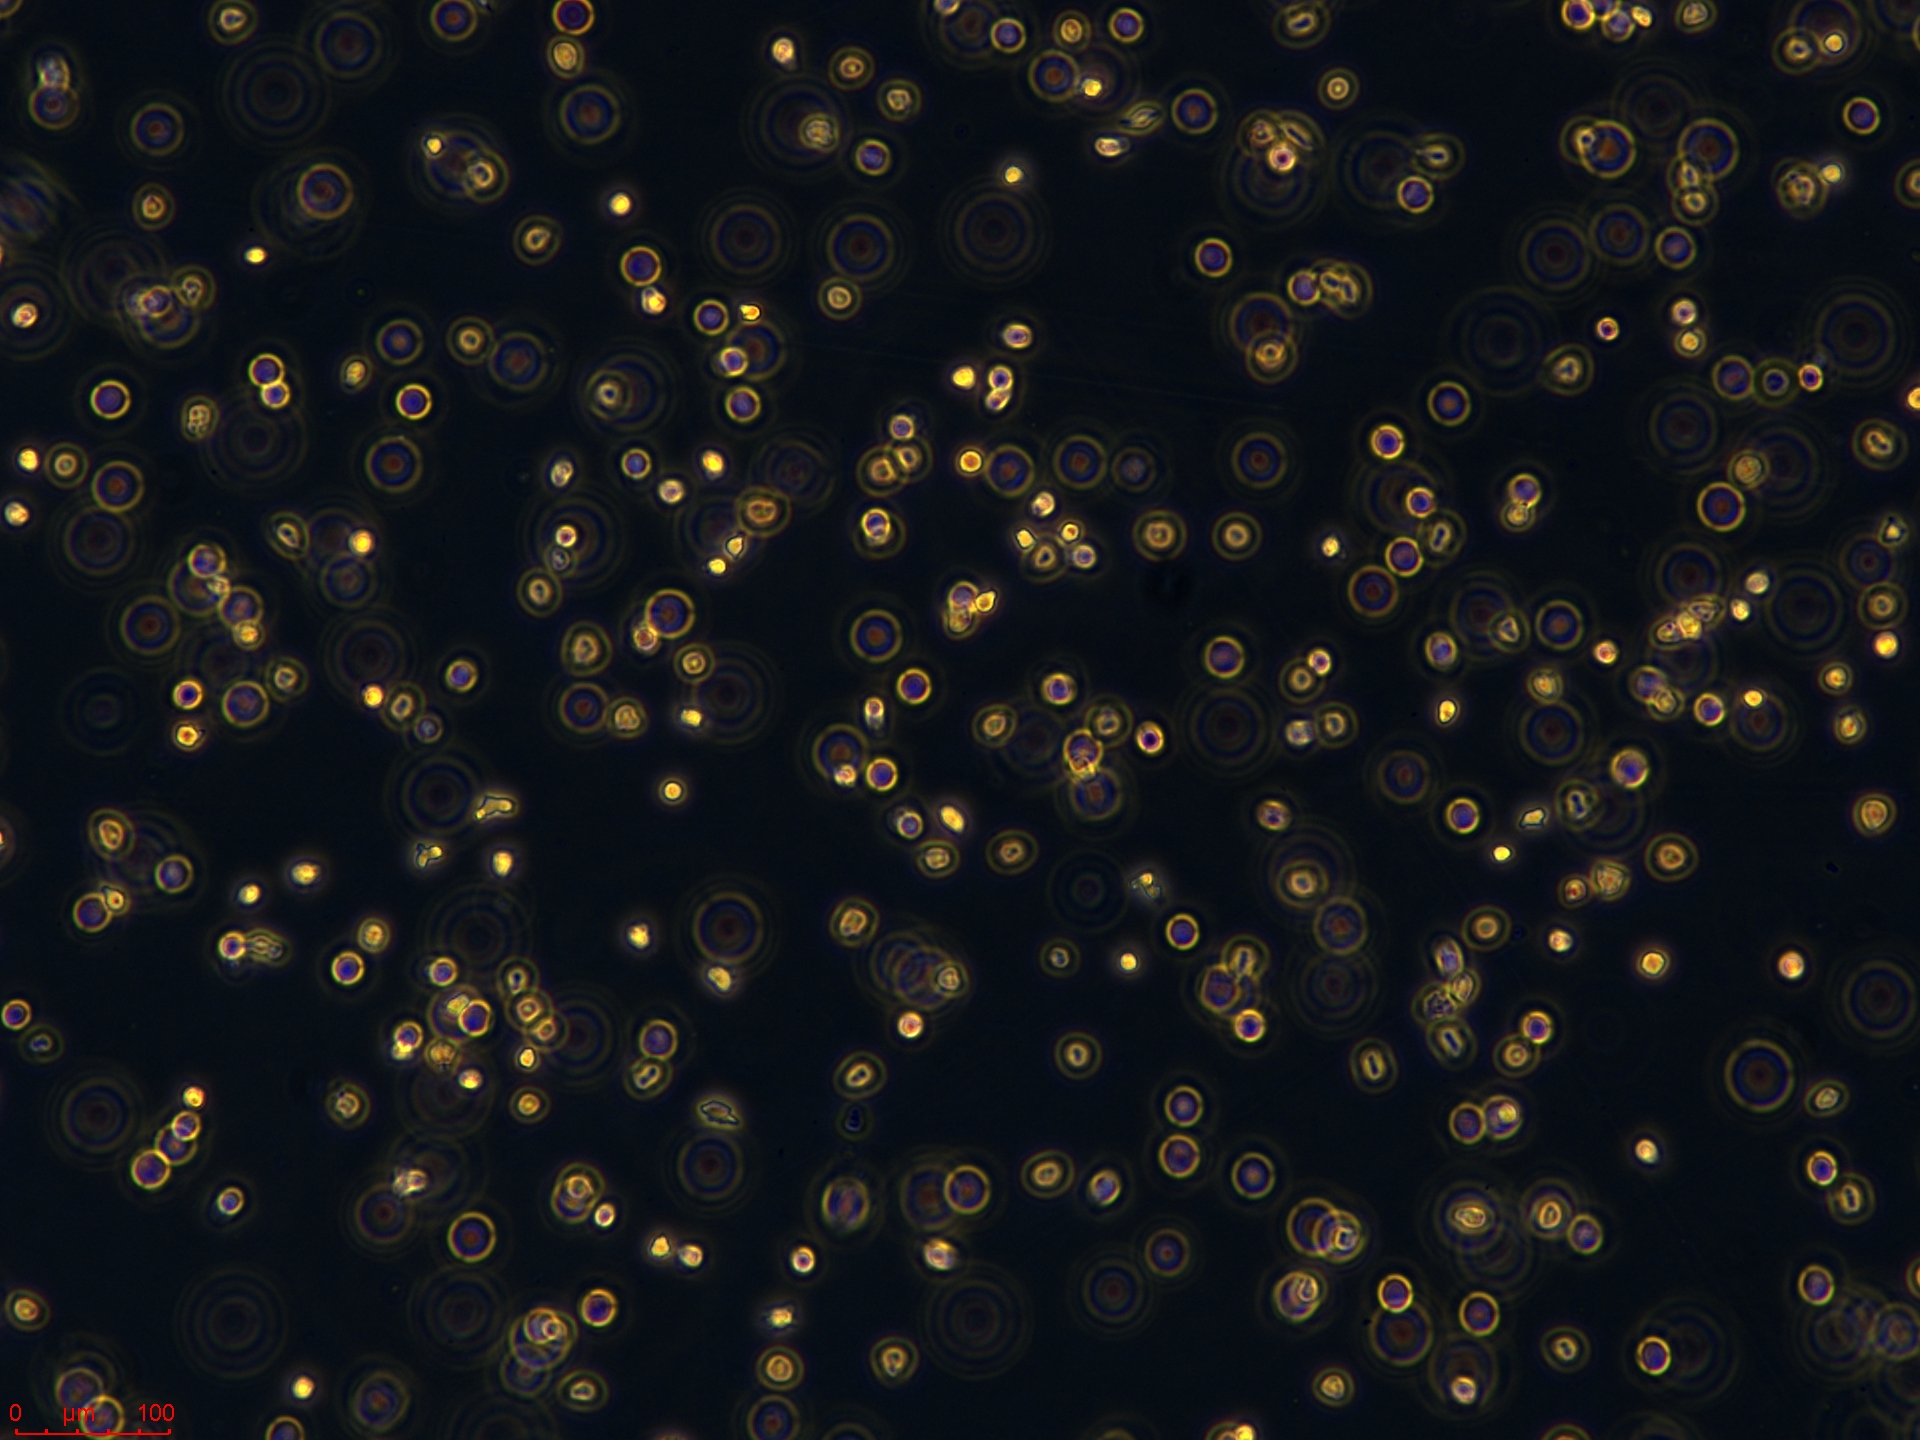
lama84 高.jpg
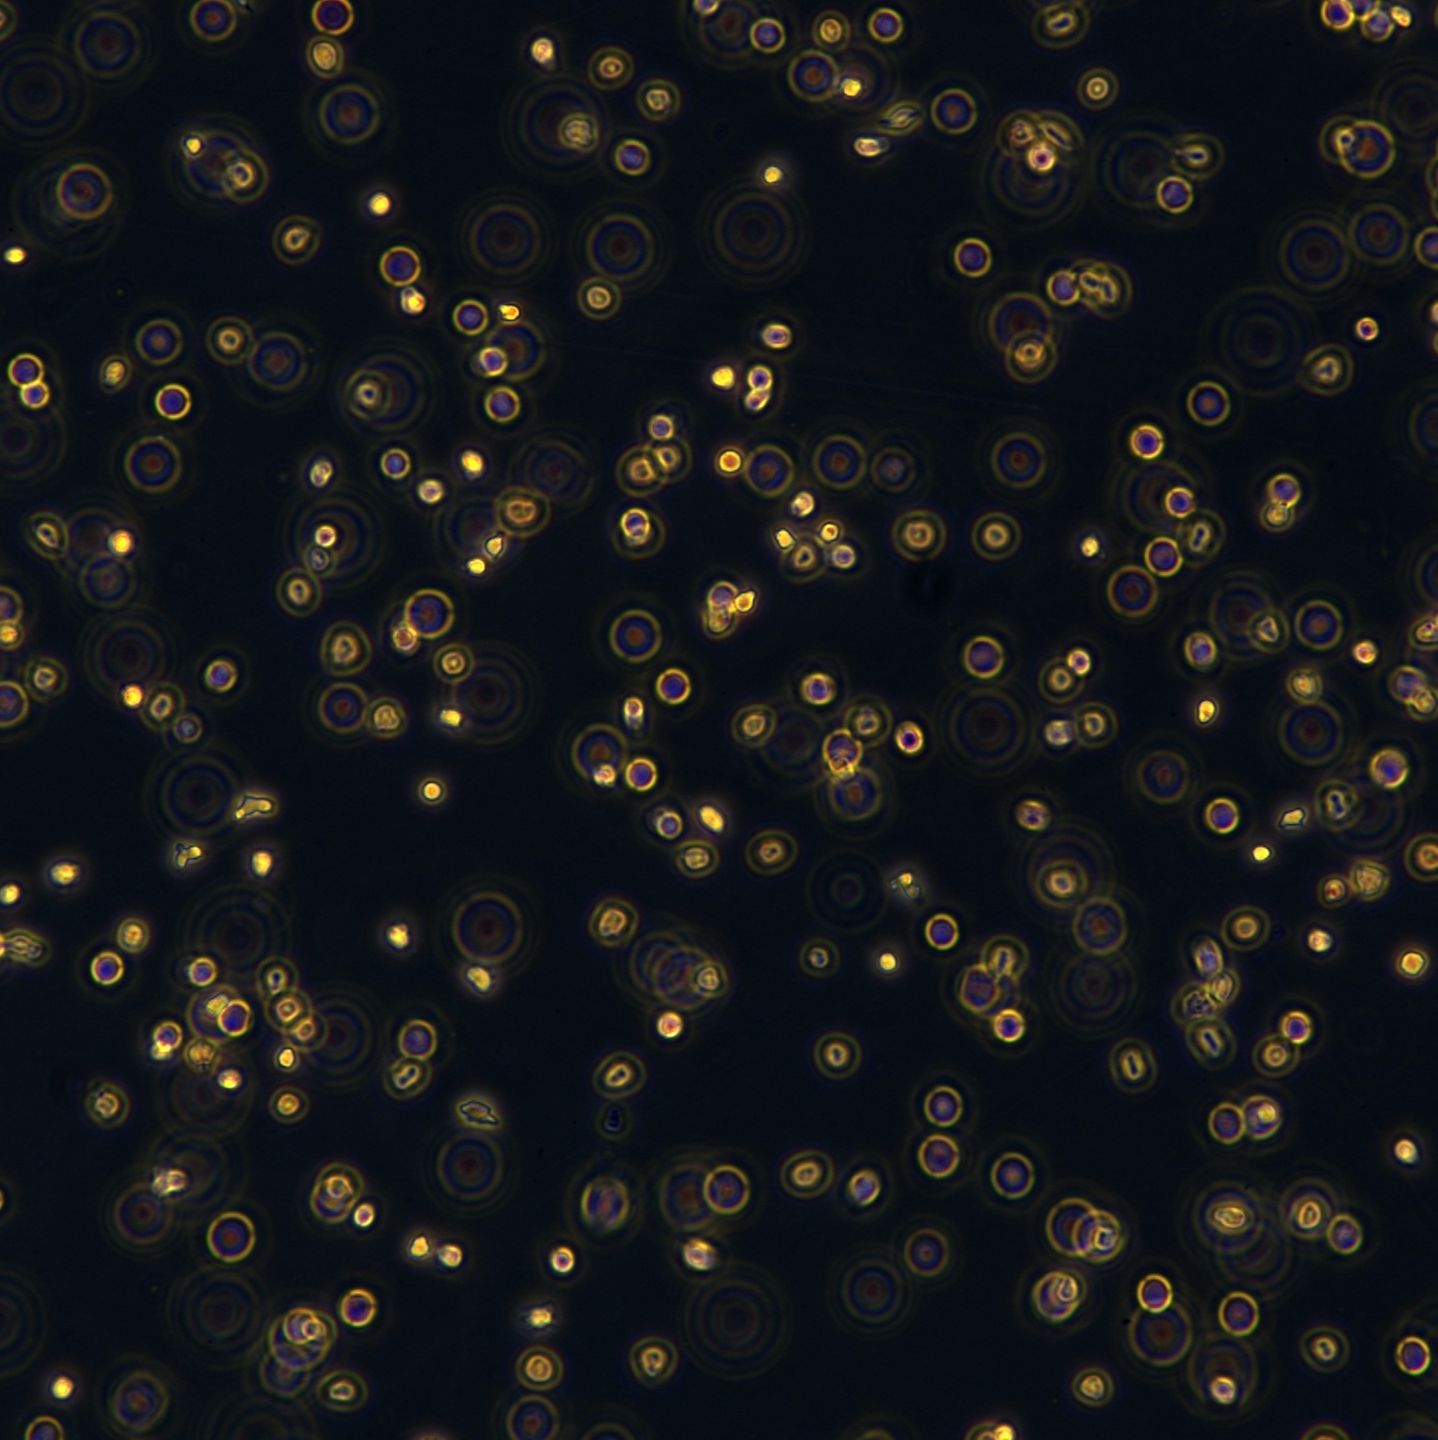
产品封面图

相关产品推荐更多 >
万千商家帮你免费找货
0 人在求购买到急需产品
- 详细信息
- 询价记录
- 文献和实验
- 技术资料
- 英文名:
LAMA84
- 组织来源:
外周血(Peripheral blood)
- 相关疾病:
慢性粒细胞白血病( Chronic myeloid leukemia)
- 物种来源:
人源(Homo sapiens)
- 运输方式:
顺丰包邮
- 年限:
29岁(29 years)
- 生长状态:
悬浮生长(Suspension)
- 规格:
T25/冻存管
LAMA-84细胞是一种重要的人慢性粒细胞白血病(CML)细胞模型,其独特价值在于它源自一位处于急变期(Blast Crisis) 的CML患者。CML的急变期是疾病的终末阶段,以髓系或淋系原始细胞急剧增殖为特征,预后极差。该细胞最显著的特征是携带CML的标志性遗传异常——费城染色体(Philadelphia Chromosome),并由此表达BCR-ABL融合癌蛋白,其类型为p210。
因此,LAMA-84被广泛用作研究CML疾病进展,特别是从慢性期向急变期转变的分子机制以及对酪氨酸激酶抑制剂产生耐药性的核心体外工具。该细胞对伊马替尼相对敏感,但也常被用于探索其耐药机制,例如BCR-ABL激酶域的突变。此外,它也是筛选新一代TKIs(如尼罗替尼、达沙替尼)、评估联合用药策略以及研究白血病干细胞生物学的重要模型,为攻克这一白血病难治阶段提供了关键的研究平台。
| 规格 | T25 |
| 货号 | CTCC-007-0246 |
| 种属 | 人源(Homo sapiens) |
| 组织来源 | 外周血(Peripheral blood) |
| 疾病 | 慢性粒细胞白血病( Chronic myeloid leukemia) |
| 年龄 | 29岁(29 years) |
| 培养体系 | 该细胞系培养所用基本培养基为 RPMI1640 Medium,配置完全培养基时 需加入20%FBS,1% Anti-Anti。 |
| 生长特性 | 悬浮生长(Suspension) |
风险提示:丁香通仅作为第三方平台,为商家信息发布提供平台空间。用户咨询产品时请注意保护个人信息及财产安全,合理判断,谨慎选购商品,商家和用户对交易行为负责。对于医疗器械类产品,请先查证核实企业经营资质和医疗器械产品注册证情况。
- 作者
- 内容
- 询问日期
 文献和实验
文献和实验对于科研人员来说,每天都要烧大把的钱以祭奠在研究过程中逝去的青春。可不是每个钱都好烧,比如文章版面费。昂贵的版面费你烧着钱做完研究,写完文章,投了稿,准备发个 SCI。在数十个日夜无止休地查询审稿状态后,你惊喜地发现文章被接受了。这时编辑部温馨地发来了提醒交版面费的邮件,你发现这版面费动不动就上万。可是不是每个课题组都有充足的经费的。于是就出现了有些小伙伴在稿件被接收后,因为版面费太贵,得不到报销支持而不得不改投其他杂志。这时候是不是有种垂死病中惊坐起,暗风吹雨入寒窗的感觉呢。此时想到一副
CD84 分子 CD84 常用单克隆抗体或代号: 2G7,152- ID5,GR6 主要表达细胞: B,M,Mac,Pt [B] 分子质量(kDa)和结构: p73 功 能:可能是一种协同刺激分子,同嗜性结合? CD84 Summary: Homophilic adhesion molecule that enhances IFN-gamma secretion
Analysis of LAMA2 Gene in Merosin- Deficient Congenital Dystrophy
Congenital muscular dystrophies (CMDs) are a clinically and genetically heterogenous group of muscle disorders, with onset in early infancy, and autosomal recessive inheritance (1 – 3 ). Several forms have been identified: classical